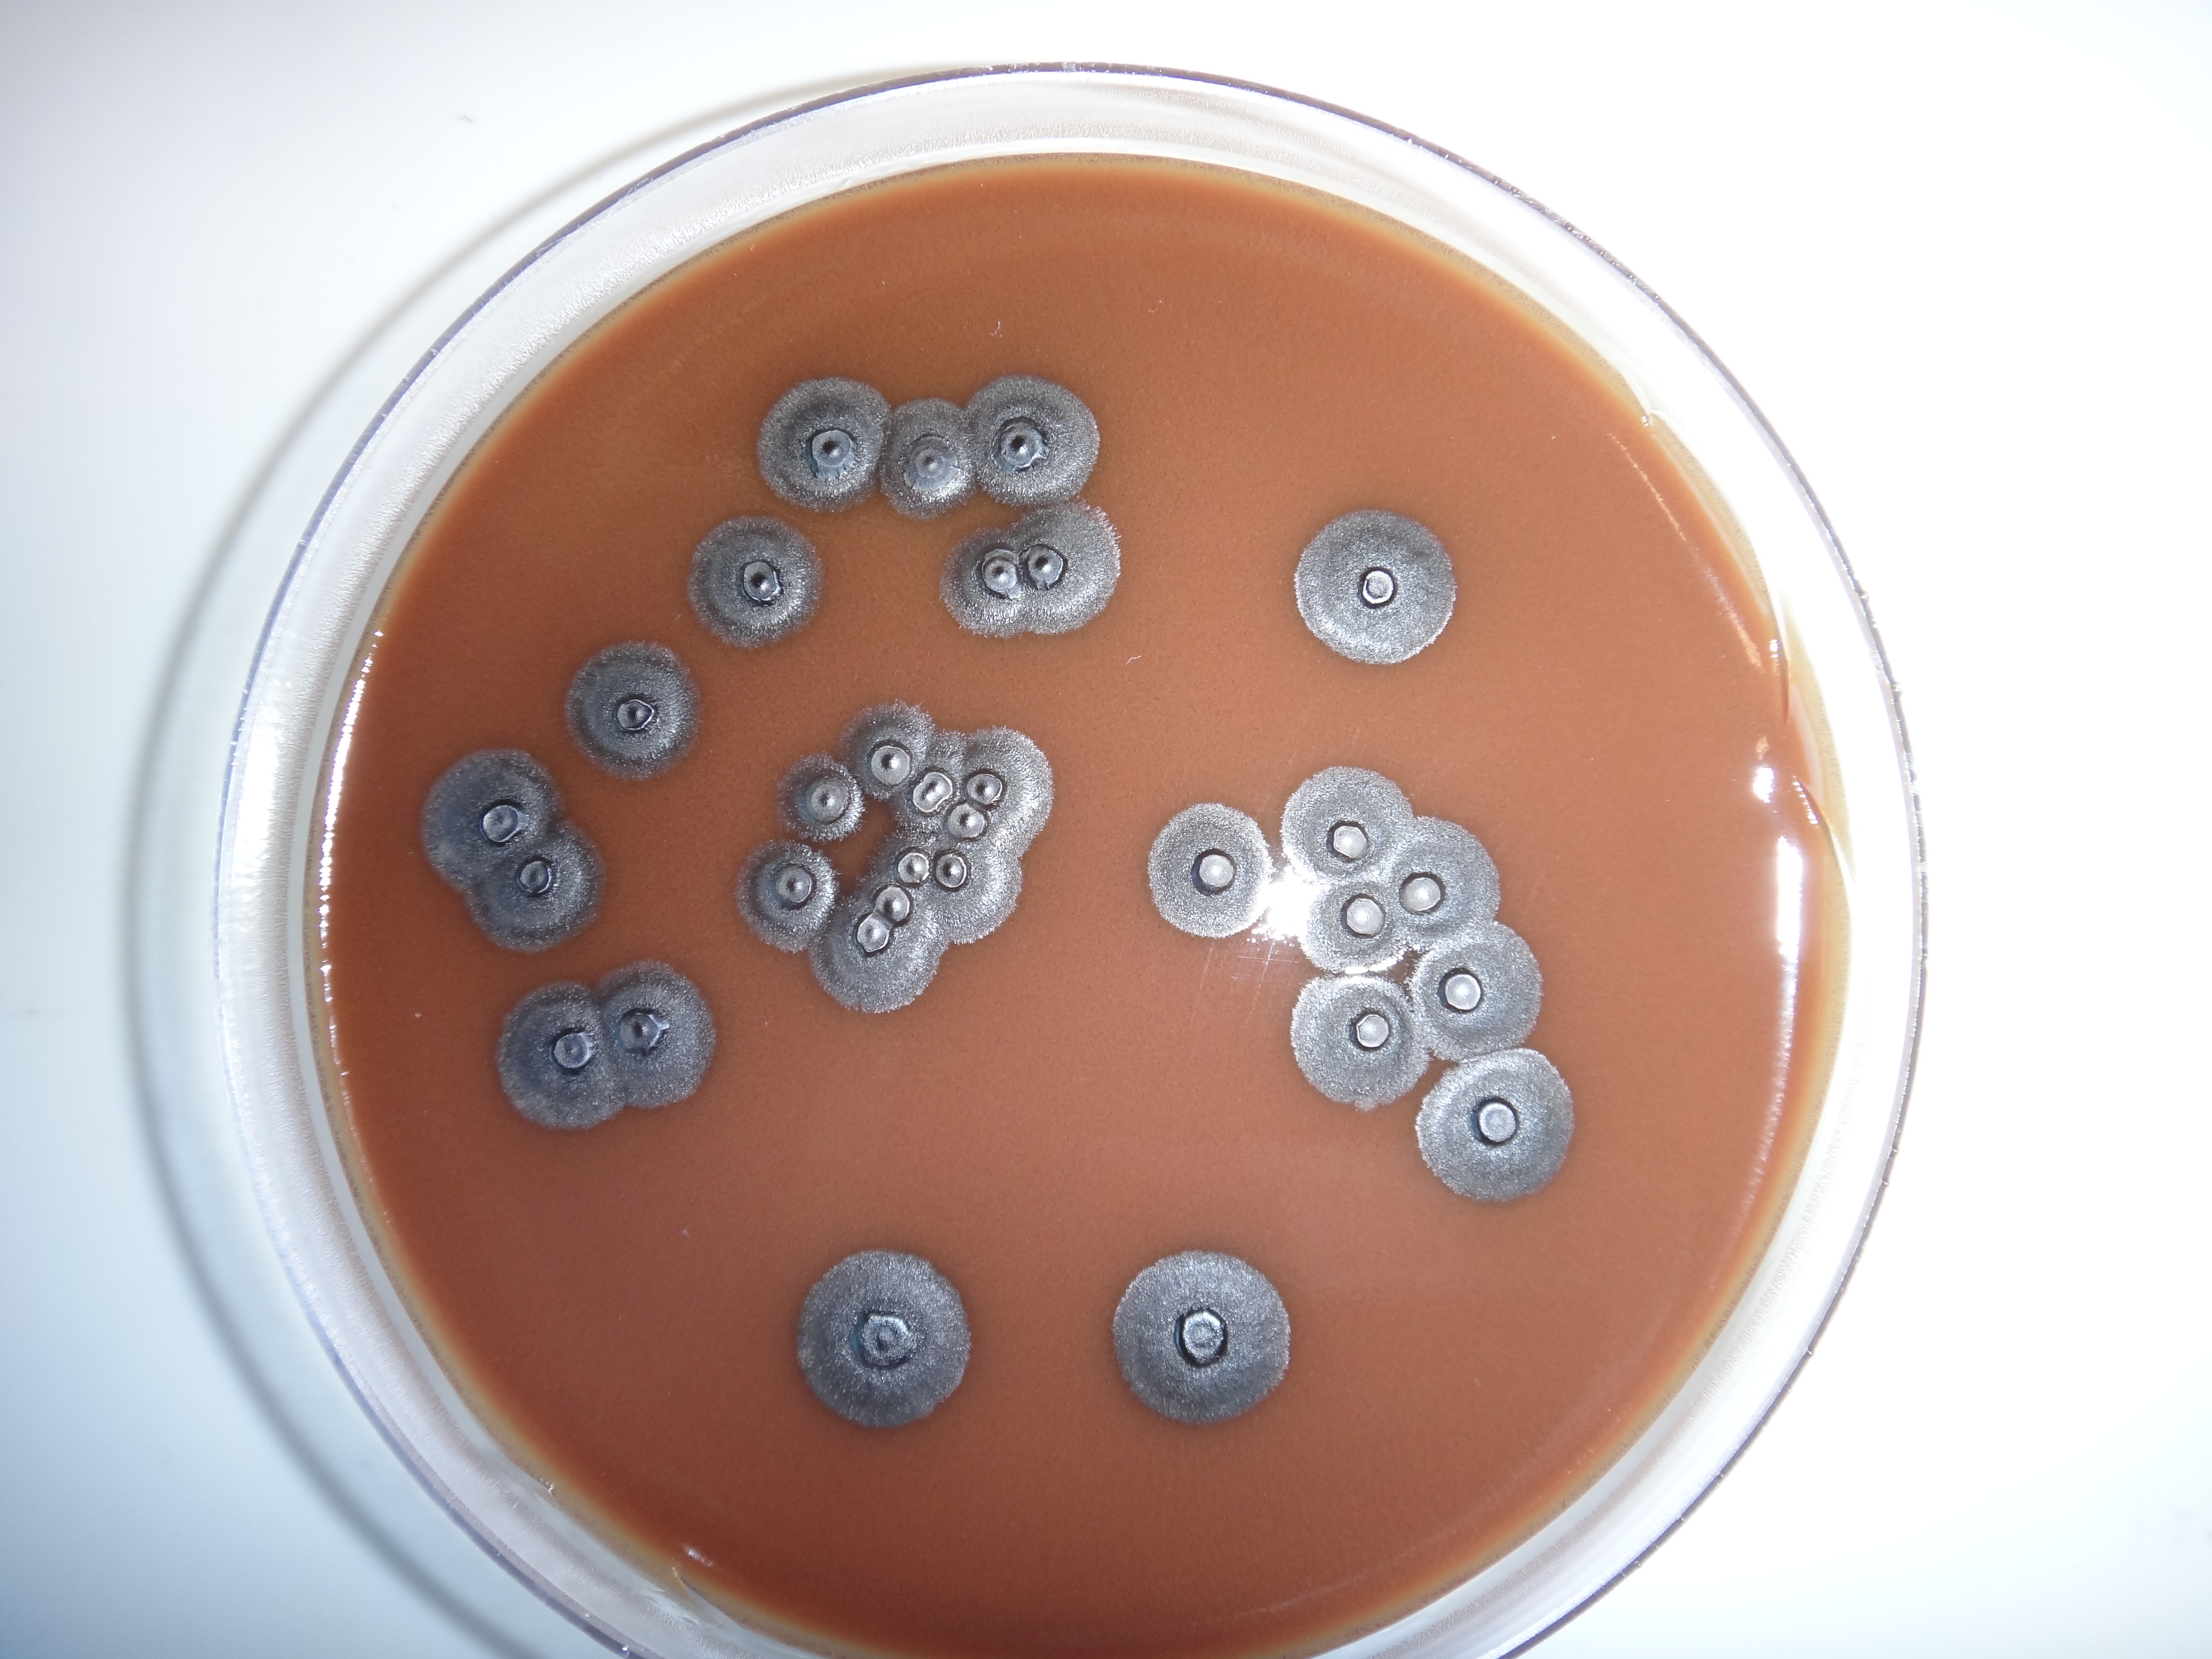

Join 550 other subscribers
Category Cloud
Abdomen/GIT Allergy AMS strategy Antibiograms Antimicrobial Bloodstream CNS Infections General Practice Guidelines Health Pathology NSW HNE LHD Hospital practice Infection prevention Infectious diseases Journal paper Microbiology Myths & Misconceptions News Patient information Respiratory Salutary tale SexuallyTxDis Skin/soft tissue Uncategorized Urinary tract infections Weird facts
Top Posts & Pages
- Is it really cellulitis? - differential diagnosis of a red leg
- Q10 - Remembering antibiotics and their classes
- Why do Gram positive and Gram negative bacteria show different antibiotic susceptibility patterns?
- What are cumulative antibiograms ?
- Outpatient staphylococcal (MSSA or MRSA) eradication instructions
- Is that second course of antibiotics really necessary?
- Cellulitis 101 - importance of routine skin care
- Sparing meropenem 101 - treatment of ESCPM species and AmpC betalactamases unpacked
- Is it cellulitis? The case of itchy red legs
- Trap - cellulitis or an acute Charcot's foot ?
Join 550 other subscribers